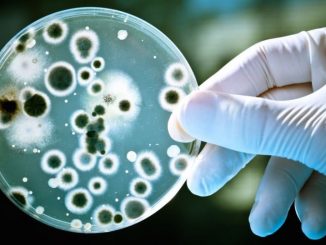
scientists

Bomb Threat Closes Munich Shopping Centre And Train Station
Munich police evacuated a shopping centre and a train station this afternoon after a tip off that a bomb was placed in the area. Pasing Arcaden shopping centre and Pasing railway station were evacuated as […]